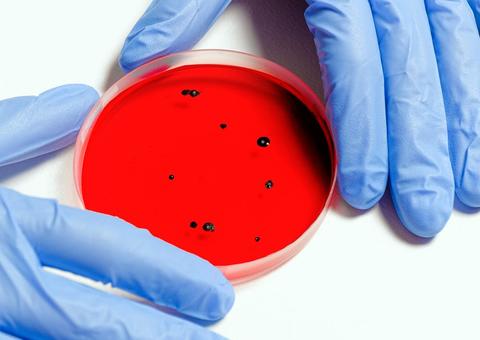
Casos de coronavírus ultrapassam 8 mil e número de mortos não para de subir no Brasil

SÃO PAULO, SP (FOLHAPRESS) - Um estudo chinês divulgado em março deste ano mostra que pessoas com Covid-19 desenvolveram problemas neurológicos como sintomas da doença.
A investigação foi realizada entre os dias 16 de janeiro e 19 de fevereiro de 2020 em 214 pacientes com Covid-19 -graves ou não- internados em três hospitais de Wuhan (China), onde começou a pandemia. Destes, 78 apresentaram alguma manifestação neurológica.Entre os sintomas, os mais comuns foram a tontura, mencionada por 36 pacientes (16,8%), e dor de cabeça, citada por 28 (13,1%).
Em seguida aparecem confusão mental, AVC ou isquemia cerebral, convulsão, perda da coordenação muscular e sonolência.
De acordo com o neurologista do Hospital Israelita Albert Einstein, Saulo Nardy Nader, trata-se do primeiro estudo bem feito sobre o acometimento neurológico por coronavírus. Para ele, a conclusão serve de alerta.
"Pessoas com quadro gripal e que apresentarem pela primeira vez algum tipo de tontura forte e persistente, principalmente vertigem, podem estar infectadas pelo coronavírus", afirma.
Nader diz que a pesquisa também traz uma queixa que está se tornando comum nos consultórios e até nas redes sociais: a perda de olfato (hiposmia) e paladar (hipogeusia). Cerca de 5% dos que apresentaram sintomas neurológicos mencionaram esse tipo de alteração.
O coronavírus pode chegar ao sistema nervoso central de duas formas. "A primeira hipótese é pelo sangue e a segunda diretamente pelo nariz, pegando carona com o nervo olfativo. A pessoa teria contato com o vírus pela narina e, através do nervo que leva informação do nariz para o cérebro, conseguiria causar a infecção. A falta de ar, por exemplo, pode ocorrer por agressão neurológica do vírus na região do cérebro responsável por controlar os centros da respiração", explica Nader.
Os sintomas elencados no estudo feito em Wuhan não são novidades nos consultórios de especialistas brasileiros ouvidos pela Folha. Além dos neurológicos, há outros incomuns.
João Prats, infectologista da BP (Beneficência Portuguesa de São Paulo) explica que, apesar de não ser comum, o primeiro sinal de infecção por coronavírus pode aparecer sob a forma de problema digestivo.
Ele cita como exemplo o caso de uma paciente que, após cinco dias com diarreia, teve dificuldade respiratória.
Quando o coronavírus circula no sangue e inflama os gânglios linfáticos abdominais, também pode ocorrer dor forte semelhante à provocada por apendicite ou cólica renal.
"Ainda não há estatística dos atendimentos, mas é a minoria. O sintoma que sugere gravidade é o respiratório, a falta de ar. Mesmo que a primeira manifestação for atípica, os médicos devem investigar mais", afirma Prats.
Após examinar uma pessoa com sintomas de covid-19, o infectologista da Unifesp (Universidade Federal de São Paulo) Paulo Olzon sentiu-se mal. Primeiro, veio o cansaço excessivo; cerca de quatro dias depois, as tonturas, com mais frequência no período noturno.
"Para mim, a tontura foi novidade, mas é importante alertar que ela é sintoma de outras doenças, como a própria labirintite, os tumores cerebrais e problemas de pressão arterial, entre outras. Para o diagnóstico, é importante levar em conta o histórico do paciente e a intensidade dos sintomas", explica Olzon, que está em isolamento. Além de tontura, ele também teve alteração do paladar e do olfato.
Para José Vidal, infectologista do Hospital das Clínicas de SP e do Instituto de Infectologia Emílio Ribas e membro da Sociedade Brasileira de Infectologia, a teoria mais provável é que o novo coronavírus infecte os nervos periféricos olfatórios causando as alterações de olfato que já vêm sendo relatadas por alguns pacientes.
"Essas alterações podem alertar para a presença do coronavírus, visando instaurar as medidas necessárias, em termos individuais e de saúde pública, como o isolamento. É necessário estudar melhor as consequências a longo prazo. A rota da infecção precisa ser melhor elucidada. O vírus também pode causar problemas cardíacos, intestinais e outras manifestações neurológicas graves, como paralisa flácida aguda, síndrome de Guillain-Barré e encefalomielite disseminada aguda, todas já descritas com outros coronavírus humanos", explica Vidal.
Segundo dados do Ministério da Saúde, o Brasil tem 241 mortes por coronavírus e 6.836 casos da doença. O estado de São Paulo tem o maior número de confirmações, com 2.981 registros. Até o momento, morreram 164 pessoas.

Aviso